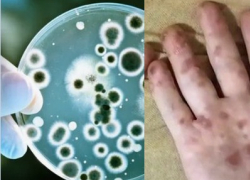
Сыпь и рвота: почти полсотни детей на Кубани подхватили что-то похожее на Коксаки

Общество
-
Около 700 контейнеров в неделю будут привозить в Новороссийск из Египта: что доставят
Между Новороссийском и Египтом будет открыта морская линия. Об этом сообщает пресс-служба Торгпредства России в Египте. Планируется, что перевозки буд...
Читать полностью...
 Порты между Новороссийском и Египтом свяжут морской линией
Около 700 контейнеров в неделю будут привозить в Новороссийск из Египта: что доставят
07.11.2024 19:00
Порты между Новороссийском и Египтом свяжут морской линией
Около 700 контейнеров в неделю будут привозить в Новороссийск из Египта: что доставят
07.11.2024 19:00
 Отопление подается, хоть его и не видят
"АТЭК" лучше знает, тепло новороссийцам или холодно
07.11.2024 18:20
Отопление подается, хоть его и не видят
"АТЭК" лучше знает, тепло новороссийцам или холодно
07.11.2024 18:20
 Поддельные сайты, ложные покупки и пустые надежды
"Заскамили мамонта": новороссийцам угрожает старая-новая схема обмана
07.11.2024 17:40
Поддельные сайты, ложные покупки и пустые надежды
"Заскамили мамонта": новороссийцам угрожает старая-новая схема обмана
07.11.2024 17:40
 С новым предложением выступили сотрудники Минюста России
Новороссийских отцов могут обязать платить алименты 23 года
07.11.2024 16:20
С новым предложением выступили сотрудники Минюста России
Новороссийских отцов могут обязать платить алименты 23 года
07.11.2024 16:20
 Чёрное море и правда становится чёрным
Цена экологии - 400 тысяч: подробности очередного разлива нефти в Новороссийске
07.11.2024 15:00
Чёрное море и правда становится чёрным
Цена экологии - 400 тысяч: подробности очередного разлива нефти в Новороссийске
07.11.2024 15:00
 Тепло должно быть в каждом доме
Губернатор Кубани узнал о проблемах с отоплением в Новороссийске
07.11.2024 14:20
Тепло должно быть в каждом доме
Губернатор Кубани узнал о проблемах с отоплением в Новороссийске
07.11.2024 14:20
 С отравлением жители попали в больницу. Среди них – беременная женщина
Грибы-убийцы: в Геленджике 10 человек чуть не умерли после грибной трапезы
07.11.2024 13:00
С отравлением жители попали в больницу. Среди них – беременная женщина
Грибы-убийцы: в Геленджике 10 человек чуть не умерли после грибной трапезы
07.11.2024 13:00
 И с этим ничего не поделать
Данные более 90% новороссийцев есть в сети: откуда берут информацию о вас
07.11.2024 12:20
И с этим ничего не поделать
Данные более 90% новороссийцев есть в сети: откуда берут информацию о вас
07.11.2024 12:20
Воспитанники детского сада «слегли» от заразной болезни
Сыпь и рвота: почти полсотни детей на Кубани подхватили что-то похожее на Коксаки
07.11.2024 11:40
Воспитанники детского сада «слегли» от заразной болезни
Сыпь и рвота: почти полсотни детей на Кубани подхватили что-то похожее на Коксаки
07.11.2024 11:40
 Спокойствие, только спокойствие!
В Новороссийске пройдут учения по уничтожению БПЛА
07.11.2024 09:45
Спокойствие, только спокойствие!
В Новороссийске пройдут учения по уничтожению БПЛА
07.11.2024 09:45
 Но с утра будет облачно
Погода в Новороссийске: улыбайтесь - солнышко пригреет жителей города
07.11.2024 07:00
Но с утра будет облачно
Погода в Новороссийске: улыбайтесь - солнышко пригреет жителей города
07.11.2024 07:00
 В Новороссийске прошли реконструкции и мастер-классы в преддверии Дня единства
0+«Невероятное зрелище!»: новороссийцы стали частью истории на «Квадрате»
06.11.2024 20:45
В Новороссийске прошли реконструкции и мастер-классы в преддверии Дня единства
0+«Невероятное зрелище!»: новороссийцы стали частью истории на «Квадрате»
06.11.2024 20:45
 Меню школьных столовых решили разнообразить.
Сахар на столах новороссийских школьников предложили заменить мёдом
06.11.2024 18:40
Меню школьных столовых решили разнообразить.
Сахар на столах новороссийских школьников предложили заменить мёдом
06.11.2024 18:40
 Это она про всех жителей в городе?
«В Новороссийске принято обманывать» - мнение женщины, прибывшей из Новокузнецка
06.11.2024 18:00
Это она про всех жителей в городе?
«В Новороссийске принято обманывать» - мнение женщины, прибывшей из Новокузнецка
06.11.2024 18:00
 Россия отменит роуминг с соседней страной
Новороссийцы смогут звонить и путешествовать в соседнюю страну без роуминга
06.11.2024 17:40
Россия отменит роуминг с соседней страной
Новороссийцы смогут звонить и путешествовать в соседнюю страну без роуминга
06.11.2024 17:40
 Услуга будет запущена на портале со следующего года
Налоговый вычет новороссийцы теперь могут получить через Госуслуги
06.11.2024 17:00
Услуга будет запущена на портале со следующего года
Налоговый вычет новороссийцы теперь могут получить через Госуслуги
06.11.2024 17:00
 Торт весил 225 килограммов
Торт за 2 миллиона испекла жительница Новороссийска для Яны Рудковской и Евгения Плющенко
06.11.2024 15:40
Торт весил 225 килограммов
Торт за 2 миллиона испекла жительница Новороссийска для Яны Рудковской и Евгения Плющенко
06.11.2024 15:40
 Прошло 17 дней с начала отопительного сезона
"Отопления нет и не было!": новороссийцы замерзают в своих домах
06.11.2024 13:40
Прошло 17 дней с начала отопительного сезона
"Отопления нет и не было!": новороссийцы замерзают в своих домах
06.11.2024 13:40
 Завораживающее природное явление заметили в Новороссийске
Температура упала к нулю: море в Новороссийске "парит"
06.11.2024 11:45
Завораживающее природное явление заметили в Новороссийске
Температура упала к нулю: море в Новороссийске "парит"
06.11.2024 11:45
 Для соцсетей потребуются документы
Интернет по паспорту могут ввести в России: на заметку новороссийцам
05.11.2024 20:35
Для соцсетей потребуются документы
Интернет по паспорту могут ввести в России: на заметку новороссийцам
05.11.2024 20:35
 Чем заняться в Новороссийске на этой неделе?
Афиша в Новороссийске с 5 до 10 ноября: «Очень простая история», музыкальный джем и книжный клуб
05.11.2024 19:50
Чем заняться в Новороссийске на этой неделе?
Афиша в Новороссийске с 5 до 10 ноября: «Очень простая история», музыкальный джем и книжный клуб
05.11.2024 19:50
 Проверять будут не только "АТЭК"
Отопление не для всех: прокуратура Новороссийска начала проверку
05.11.2024 17:00
Проверять будут не только "АТЭК"
Отопление не для всех: прокуратура Новороссийска начала проверку
05.11.2024 17:00
 Ноябрь не согреет жителей Новороссийска
В Краснодарском крае ожидаются ночные заморозки: что насчёт Новороссийска
05.11.2024 16:20
Ноябрь не согреет жителей Новороссийска
В Краснодарском крае ожидаются ночные заморозки: что насчёт Новороссийска
05.11.2024 16:20
 Ложка дегтя в «бочке с хамсой»: гости феста не смогли отыскать биотуалеты
Новороссийцы негодуют: на «Фестивале хамсы» в Новороссийске не работали туалеты?
05.11.2024 15:00
Ложка дегтя в «бочке с хамсой»: гости феста не смогли отыскать биотуалеты
Новороссийцы негодуют: на «Фестивале хамсы» в Новороссийске не работали туалеты?
05.11.2024 15:00
 В 4 домах отключили тепло и электричество
"АТЭК" 3 часа ехал на утечку: новороссийцы дышали вонючим паром без света и тепла
05.11.2024 13:40
В 4 домах отключили тепло и электричество
"АТЭК" 3 часа ехал на утечку: новороссийцы дышали вонючим паром без света и тепла
05.11.2024 13:40
 Глава Новороссийска поделился промежуточными результатами
Андрей Кравченко поставил на контроль ситуацию с отключениями в Новороссийске
05.11.2024 12:20
Глава Новороссийска поделился промежуточными результатами
Андрей Кравченко поставил на контроль ситуацию с отключениями в Новороссийске
05.11.2024 12:20
 13 отключений произошли в Новороссийске 4 ноября
День народных отключений: праздник в Новороссийске прошел с размахом
05.11.2024 11:45
13 отключений произошли в Новороссийске 4 ноября
День народных отключений: праздник в Новороссийске прошел с размахом
05.11.2024 11:45
 Напомним, отопительный сезон в Новороссийске начался 21 октября
«АТЭК» продолжает готовить Новороссийск к отопительному сезону 5 ноября
05.11.2024 09:45
Напомним, отопительный сезон в Новороссийске начался 21 октября
«АТЭК» продолжает готовить Новороссийск к отопительному сезону 5 ноября
05.11.2024 09:45
 Череда отключений продолжается
В Борисовке и Цемдолине отключили свет на неизвестный срок
05.11.2024 08:35
Череда отключений продолжается
В Борисовке и Цемдолине отключили свет на неизвестный срок
05.11.2024 08:35
 Сказать, что я офонарел, это ничего не сказать!
Новороссийцу отказали в работе из-за расклада карт таро
03.11.2024 17:50
Сказать, что я офонарел, это ничего не сказать!
Новороссийцу отказали в работе из-за расклада карт таро
03.11.2024 17:50
 О чем кино?
В Новороссийске завершились съемки фильма, основанного на реальных событиях
03.11.2024 16:36
О чем кино?
В Новороссийске завершились съемки фильма, основанного на реальных событиях
03.11.2024 16:36
 Что в них подозрительного?
С лимонами из Турции в Новороссийск прибыло опасное насекомое
03.11.2024 15:19
Что в них подозрительного?
С лимонами из Турции в Новороссийск прибыло опасное насекомое
03.11.2024 15:19
 Подписан приказ
Реконструкцию мусорного полигона в Новороссийске перенесли на 2025 год
03.11.2024 12:46
Подписан приказ
Реконструкцию мусорного полигона в Новороссийске перенесли на 2025 год
03.11.2024 12:46
 Инвалиды, которые даже не хромают
Бизнес с протянутой рукой: в Новороссийске промышляют попрошайки
03.11.2024 11:30
Инвалиды, которые даже не хромают
Бизнес с протянутой рукой: в Новороссийске промышляют попрошайки
03.11.2024 11:30
 Почему передумали?
Власти передумали отключать воду новороссийцам: почему и надолго ли
03.11.2024 10:14
Почему передумали?
Власти передумали отключать воду новороссийцам: почему и надолго ли
03.11.2024 10:14
 Что принесёт сегодняшний день?
Гороскоп от «Блокнота» на 3 ноября: у стрельцов мелкие неприятности, а козерогам лучше избегать трат
03.11.2024 09:00
Что принесёт сегодняшний день?
Гороскоп от «Блокнота» на 3 ноября: у стрельцов мелкие неприятности, а козерогам лучше избегать трат
03.11.2024 09:00
 Прогноз погоды в Новороссийске на 3 ноября
Погода в Новороссийске: неожиданно и неприятно
03.11.2024 07:00
Прогноз погоды в Новороссийске на 3 ноября
Погода в Новороссийске: неожиданно и неприятно
03.11.2024 07:00
 Что нужно обязательно сделать в этот день?
День Казанской иконы Божией Матери отметят православные новороссийцы: суть и традиции праздника
02.11.2024 19:15
Что нужно обязательно сделать в этот день?
День Казанской иконы Божией Матери отметят православные новороссийцы: суть и традиции праздника
02.11.2024 19:15
 Популярность Краснодарского края растет
Туристы бронируют отели на Черном море на 2025 год
02.11.2024 18:00
Популярность Краснодарского края растет
Туристы бронируют отели на Черном море на 2025 год
02.11.2024 18:00
 Службы Новороссийска работают в особом режиме
Ливень, ветер, шторм: в Новороссийске ввели режим повышенной готовности
02.11.2024 15:00
Службы Новороссийска работают в особом режиме
Ливень, ветер, шторм: в Новороссийске ввели режим повышенной готовности
02.11.2024 15:00
 По уровню загрязнения Новороссийск обогнал город-курорт Сочи
Новороссийск вошел в ТОП-5 городов с самым грязным воздухом
02.11.2024 12:20
По уровню загрязнения Новороссийск обогнал город-курорт Сочи
Новороссийск вошел в ТОП-5 городов с самым грязным воздухом
02.11.2024 12:20
 О том, на каком этапе находится объект, рассказал Глава Новороссийска.
Школы на 1100 мест в Натухаевке и в Раевке: станичные школьники за парты сядут нескоро
02.11.2024 11:40
О том, на каком этапе находится объект, рассказал Глава Новороссийска.
Школы на 1100 мест в Натухаевке и в Раевке: станичные школьники за парты сядут нескоро
02.11.2024 11:40
 Жители территории также жалуются на постоянные скачки напряжения.
"Кто балуется?":Цемдолина в преддверии праздников вновь осталась без света
02.11.2024 10:20
Жители территории также жалуются на постоянные скачки напряжения.
"Кто балуется?":Цемдолина в преддверии праздников вновь осталась без света
02.11.2024 10:20
 И что, что лето уже закончилось?
Где дешевле всего отдыхать на Черном море? ТОП-10 экономных курортов
01.11.2024 19:00
И что, что лето уже закончилось?
Где дешевле всего отдыхать на Черном море? ТОП-10 экономных курортов
01.11.2024 19:00
 Сценарии одни и те же
"Брокер" развел 62-летнюю женщину из Новороссийска на миллион
01.11.2024 18:20
Сценарии одни и те же
"Брокер" развел 62-летнюю женщину из Новороссийска на миллион
01.11.2024 18:20
 Запрещающие знаки поставят в ноябре
По набережной Новороссийска все-таки запретят ездить на самокатах
01.11.2024 17:00
Запрещающие знаки поставят в ноябре
По набережной Новороссийска все-таки запретят ездить на самокатах
01.11.2024 17:00
 Но получится ли компенсировать траты?
Новороссийцы могут получить перерасчет за отопление, которого нет
01.11.2024 09:45
Но получится ли компенсировать траты?
Новороссийцы могут получить перерасчет за отопление, которого нет
01.11.2024 09:45
 Любителям сладкого придется начать экономить
Сладкоежки Новороссийска, держитесь: сладости подорожают до 50%
31.10.2024 20:35
Любителям сладкого придется начать экономить
Сладкоежки Новороссийска, держитесь: сладости подорожают до 50%
31.10.2024 20:35
 Имущество и деньги, нажитые на нелегалах, будут конфисковывать - принят еще один закон.
В Новороссийске не смогут "наживаться" на нелегалах: все будут конфисковывать
31.10.2024 20:00
Имущество и деньги, нажитые на нелегалах, будут конфисковывать - принят еще один закон.
В Новороссийске не смогут "наживаться" на нелегалах: все будут конфисковывать
31.10.2024 20:00
 Новый год не ждет
Мэрия Новороссийска потратит 650 тысяч на Дедов Морозов и Снегурочек
31.10.2024 19:30
Новый год не ждет
Мэрия Новороссийска потратит 650 тысяч на Дедов Морозов и Снегурочек
31.10.2024 19:30
 Не обманешь — не проживешь
Способ покупать товары дешевле нашла жительница Новороссийска: полиция не оценила
31.10.2024 18:20
Не обманешь — не проживешь
Способ покупать товары дешевле нашла жительница Новороссийска: полиция не оценила
31.10.2024 18:20
 Новороссийские парадоксы
Новороссийск станет лучше для отдыхающих: грозит ли городу "овертуризм"
31.10.2024 17:40
Новороссийские парадоксы
Новороссийск станет лучше для отдыхающих: грозит ли городу "овертуризм"
31.10.2024 17:40
 Но выезд - все-таки не панацея
Многоквартирник подмывает кипятком в Новороссийске: внимание обратили власти района
31.10.2024 15:40
Но выезд - все-таки не панацея
Многоквартирник подмывает кипятком в Новороссийске: внимание обратили власти района
31.10.2024 15:40
 На выходных в Новороссийске будет интересно
Афиша в Новороссийске с 1 по 4 ноября: Хамса-Фест, День народного единства и «Преступник поневоле»
31.10.2024 15:00
На выходных в Новороссийске будет интересно
Афиша в Новороссийске с 1 по 4 ноября: Хамса-Фест, День народного единства и «Преступник поневоле»
31.10.2024 15:00
 На Новороссийск обрушатся ветра
Предупреждаем: мощный ветер и дожди могут накрыть Новороссийск в эти выходные
31.10.2024 14:20
На Новороссийск обрушатся ветра
Предупреждаем: мощный ветер и дожди могут накрыть Новороссийск в эти выходные
31.10.2024 14:20
 Новороссийск на пороге коммунального "апокалипсиса"
"Коммунальный коллапс": о проблемах Новороссийска выпустили репортаж
31.10.2024 13:40
Новороссийск на пороге коммунального "апокалипсиса"
"Коммунальный коллапс": о проблемах Новороссийска выпустили репортаж
31.10.2024 13:40
 Когда оно появится - точных сроков нет
Андрей Кравченко: 171 дом Новороссийска не получает отопление
31.10.2024 13:00
Когда оно появится - точных сроков нет
Андрей Кравченко: 171 дом Новороссийска не получает отопление
31.10.2024 13:00
 Жителей призвали закрыть газовые вентили
Глава Приморского района прокомментировал отключение газа в Новороссийске
31.10.2024 12:20
Жителей призвали закрыть газовые вентили
Глава Приморского района прокомментировал отключение газа в Новороссийске
31.10.2024 12:20
 Ужасающие кадры с производства облетели интернет
Бананы, похожие на кал: из этого делают выпечку для новороссийцев?
31.10.2024 11:00
Ужасающие кадры с производства облетели интернет
Бананы, похожие на кал: из этого делают выпечку для новороссийцев?
31.10.2024 11:00
 Пенсии, блогинг, майнинг и не только
Что изменится в жизни новороссийцев с 1 ноября: новые законы
31.10.2024 10:20
Пенсии, блогинг, майнинг и не только
Что изменится в жизни новороссийцев с 1 ноября: новые законы
31.10.2024 10:20
 На следующий год вновь ожидается скачок цен на продукты
Готовьте деньги: продукты в Новороссийске могут подорожать на 8-20% в 2025 году
31.10.2024 09:45
На следующий год вновь ожидается скачок цен на продукты
Готовьте деньги: продукты в Новороссийске могут подорожать на 8-20% в 2025 году
31.10.2024 09:45
 Плановые отключения в Новороссийске на 31 октября
Готовьтесь: что и кому отключат в Новороссийске 31 октября
30.10.2024 20:35
Плановые отключения в Новороссийске на 31 октября
Готовьтесь: что и кому отключат в Новороссийске 31 октября
30.10.2024 20:35
 Небывалый скачок цен на сливочное масло новороссийцы ощутили на себе.
Россияне начали воровать масло, а на Кубани – подделывать: что с Новороссийском
30.10.2024 19:30
Небывалый скачок цен на сливочное масло новороссийцы ощутили на себе.
Россияне начали воровать масло, а на Кубани – подделывать: что с Новороссийском
30.10.2024 19:30










































